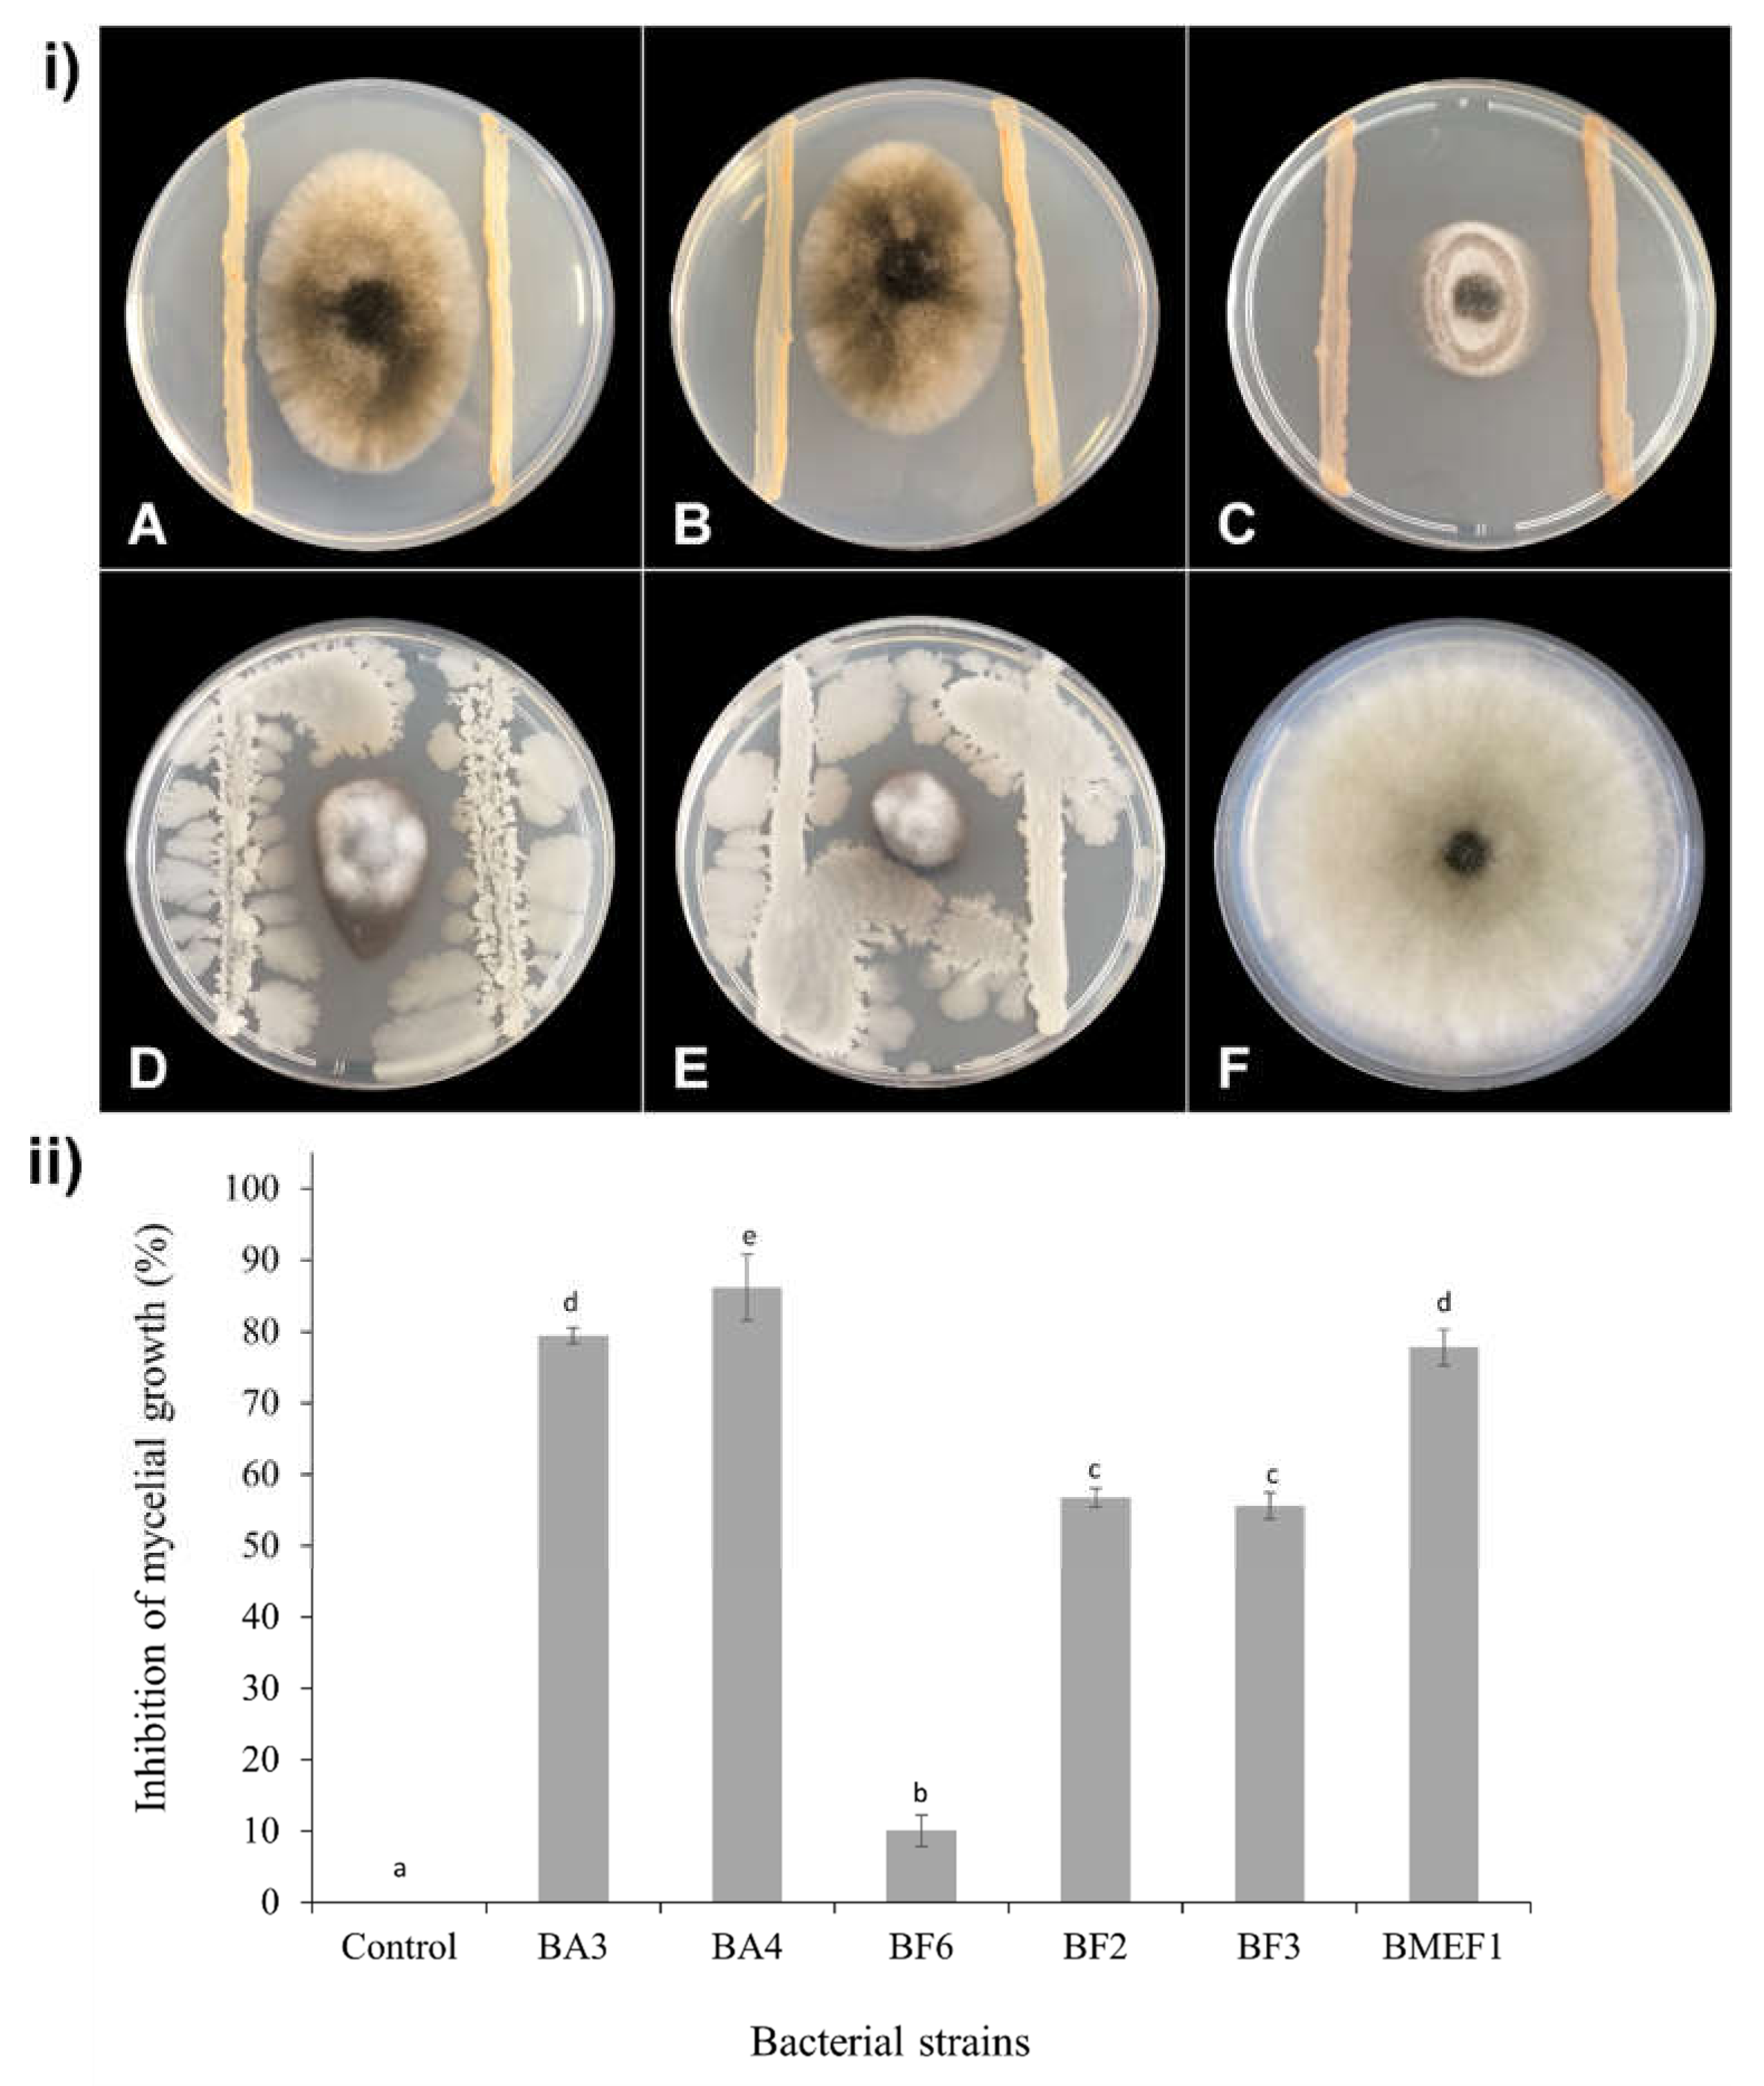
Microorganisms 10 00969 g002

Abstract
Blueberry production is affected by fungal postharvest pathogens, including Botrytis cinerea and Alternaria alternata, the causative agents of gray mold disease and Alternaria rot, respectively. Biocontrol agents adapted to blueberries and local environments are not known to date. Here, we report on the search for and the identification of cultivable blueberry epiphytic bacteria with the potential to combat the aforementioned fungi. Native, blueberry-borne bacterial strains were isolated from a plantation in Tucumán, Argentina and classified based on 16S rRNA gene sequences. Antagonistic activities directed at B. cinerea and A. alternata were studied in vitro and in vivo. The 22 bacterial strains obtained could be attributed to eleven different genera: Rosenbergiella, Fictibacillus, Bacillus, Pseudomonas, Microbacterium, Asaia, Acinetobacter, Curtobacterium, Serratia, Sphingomonas and Xylophilus. Three strains displaying antagonistic impacts on the fungal pathogens were identified as Bacillus velezensis (BA3 and BA4) and Asaia spathodeae (BMEF1). These strains are candidates for biological control agents of local blueberry production and might provide a basis for the development of eco-friendly, sustainable alternatives to synthetic pesticides.
1. Introduction
Blueberry (Vaccinium corymbosum L.), a plant belonging to the Ericaceae [1], has recently gained great commercial significance, which is not only due to the utile nutritional properties of the berries, but also—and at least equally importantly—their proven beneficial health effects. Ingredients such as polyphenols, anthocyanins, and phenolic acids account for the latter. Their health-promoting effects include prevention of diabetes, hyperlipidemia, hypertension, neurodegeneration, obesity, and osteoporosis. In addition, anti-inflammatory, antioxidant, and anticarcinogenic properties have been described [2,3,4,5].
In Argentina, production substantially increased within the last decade; nowadays, it is no. 7 worldwide with respect to blueberry harvest. The annual production of 18,000 tn is almost totally (95%) exported, especially to the United States, the Netherlands, and Germany [6,7].
Botrytis cinerea and Alternaria alternata, the causal agents of gray mold and Alternaria rot, respectively, are the most commercially significant postharvest fungal pathogens responsible for crop losses of fruits [8,9,10]. The B. cinerea infection is typically characterized by a soft rot brought about by water soaking and, finally, the collapse of tissues, rapidly followed by a massive formation of gray conidia on fruit surfaces [11,12]. A. alternata-infested berries display soft tissues along with a whitish, airy mycelium on the fruit surface; after two to three days, the hyphae fatten up and become olive green, brown, or black [13,14,15].
Countermeasures aimed at prevention of postharvest fungal fruit decay traditionally include fungicides such as anilinopyrimidines, phenylpyrrol, hydroxyanilides, and carboximides [16,17,18]. In addition to a possible upcoming ban on artificially synthesized fungicides, the extensive use of chemical compounds in agriculture entails a number of disadvantages, such as the increasing public concern of their toxicity along with severe negative environmental impacts, the emergence of resistant phytopathogenic strains, and expectable trade barriers. Thus, emphasis was placed on the development of novel, sustainable, eco-friendly, and safe biocontrol technologies [19,20,21].
Biological control is one of the most potent alternatives to synthetic fungicides, especially as the implementation of native epiphytic microorganisms to combat postharvest pathogens has proved successful [22]. Organisms colonizing the respective ecological niche not only show the adaptive advantages of candidate microbes, but also increase public acceptance [23]. To date, several bacteria-based biocontrol agents are commercially available, such as BioSave® or Serenade®; both biocontrol formulations employ prokaryotes, i.e., Pseudomonas syringae ESC-10 and Bacillus subtilis QST-713, respectively. Although—amongst others (such as strawberry and grape)—the above microorganisms also bear the potential to protect blueberries [24], native specimens adapted to the corresponding local fruit environment and, at the same time, displaying potential biocontrol capacities are not yet known.
The aim of this study was the isolation and evaluation of epiphytic bacteria from the blueberry microbiome with the potential to combat the most harmful blueberry postharvest fungal phytopathogens.
2. Materials and Methods
2.1. Sample Collection
Fruits and flowers belonging to Snowchaser blueberry cultivars were collected from plantations belonging to the Tierra de Arándanos company in Monteros, Tucumán, Argentina. Samples without any preharvest treatment with synthetic products (herbicides, pesticides) were transported to the laboratory in sterile bags using a cooler box. Permission to conduct these studies was granted by the local authority: “Dirección de Flora, Fauna Silvestre y Suelos” (Department of Flora, Fauna and Soils), Tucumán, Resolution N° 20-2022 (DFFSyS).
2.2. Cultures and Preparation of Conidial Suspensions of the Pathogens
Phytopathogenic strains of B. cinerea ISIB-MMA/F-Bc01-S and A. alternata ISIB-MMA/F-Alsp19-S were obtained from the strain collection of INSIBIO-CONICET (Higher Institute of Biological Research) in Tucumán, Argentina.
Conidial suspensions were prepared by collecting conidiospores from a 10-day culture grown on PDA medium (4 g L−1 potato extract, 20 g L−1 glucose, 15 g L−1 agar, pH 5.6) at 25 °C. Standard saline solution containing 0.1% Tween 80 was evenly spread on the surface of the mycelia and gently scraped employing a sterile loop to ensure conidial harvesting. The obtained conidial suspensions were adjusted to a concentration of 106 conidia mL−1 using a Neubauer’s counting chamber.
2.3. Isolation of Bacteria
Flower and fruit (20 g) samples were placed in sterile flasks containing 100 mL of the above saline solution with 0.1% Tween 80. The flasks were vigorously shaken (200 rpm) for 30 min in an orbital shaker (Biomint, Buenos Aires, Argentina). Subsequently, 100 µL samples were ten-fold serially diluted and plated on two different isolation media—(i) LB-agar medium (5 g L−1 yeast extract, 10 g L−1 tryptone, 10 g L−1 NaCl, 15 g L−1 agar, pH 7) and (ii) LBAr medium (500 mL L−1 blueberry juice, 0.25 g L−1 yeast extract, 5 g L−1 tryptone, 5 g L−1 NaCl, 15 g L−1 agar)—both of which were supplemented with 50 mg L−1 cycloheximide to prevent fungal growth. The plates were incubated at 25 °C for up to 72 h. Single colonies showing different macroscopic appearances were isolated and the bacterial morphology determined by microscopy and Gram staining. Pure cultures of each bacterial isolate were conserved in LB-medium containing 20% glycerol and kept at −80 °C for long-term storage.
2.4. Assaying the In Vitro Antagonistic Activity against Blueberry Pathogenic Fungi
Inhibitory effects on the mycelial growth of B. cinerea and A. alternata of all the isolates were primarily assessed in vitro, applying a slightly modified dual culture assay [25]. Briefly, 100 µL of the conidial suspension (106 conidia mL−1) was seeded on PDA plates (90 mm diameter); subsequently, 5 µL of the respective bacterial suspension (108 to 109 CFU mL−1) grown to the late exponential phase in LB was spotted on equidistant sites of the plate. Each experimental setting was done in triplicate. The plates were evaluated in daily intervals. Samples causing growth inhibition were classified as antagonists and selected for further analysis.
The selected bacterial candidates were tested individually in order to quantify the inhibition potential with respect to the mycelial growth of the phytopathogens by applying the more accurate parallel streak method according to the protocol given in De Lima et al. (2012) [26] with some modifications: 5 µL samples of the phytopathogen conidial suspension were spotted in the center of a PDA plate (90 mm diameter). A loopful of the bacterial isolate to be tested was streaked on each of two sites adjacent to the phytopathogen, at a distance of 20 mm to the plate edge. The controls consisted of PDA plates solely inoculated with the fungus. Petri dishes were incubated at 25 °C until the fungal growth of controls reached the plate edge, which took 10 days in the case of B. cinerea and 7 days for A. alternata. After incubation, the radial growth was measured, and the inhibition percentage was calculated as the percentage of colony radial growth decrease compared to the control.
2.5. In Vivo Biocontrol Efficiency
The efficiency of the selected bacterial isolates in blueberry protection against B. cinerea was assessed as described by Olmedo (2017) [27] with some modifications. Bacterial cultures were grown in LB broth for 24 h at 25 °C and 180 rpm and bacterial suspensions (108 to 109 CFU mL−1) were directly used to treat fruits. Blueberries (3 replicates of 10 berries each) were wounded in the equatorial zone with a sanitized needle and disposed in clean plastics trays. Then, the fruits were treated with the tested bacterial suspension by aspersion (for 10 fruits, 3 mL of bacterial suspension was used) and were incubated for 24 h at 25 °C before being infected by the fungal phytopathogen. A fungal conidial suspension (106 conidia mL−1) was used to artificially infect the fruits by spraying. These infected berries were further incubated in plastic trays for 7 days at 25 °C and 95% relative humidity. The controls consisted of wounded blueberries treated solely with LB medium and B. cinerea. The protection efficiency was evaluated and calculated as the number of healthy berries per treatment using the following equation:
2.6. Molecular Identification of Bacterial Isolates
The identification of isolates from blueberries was carried out by sequencing a fragment of the 16S rRNA gene. Thus, the gene of 16S rRNA, which has approximately 1500 bp, was amplified for each isolate [28]. The strains were grown in 15 mL LB medium (10 g L−1 tryptone, 10 g L−1 NaCl, 5 g L−1 yeast extract) at 25 °C and 180 rpm in an orbital shaker (Biomint, Buenos Aires, Argentina) for 48 h. The cells were harvested by centrifugation (10,000× g for 5 min), and DNA extractions were carried out using a genomic DNA extraction kit (QIAamp DNA Kit, Qiagen, Hilden, Germany) according to the manufacturer´s protocol. Such DNA samples were used as the template for PCR amplification employing universal primers 8F (5′-AGAGTTTGATCCTGGC-3′) and 1504R (5′- TACCTTGTTACGACTT- 3′) [29]. The sizes of all amplification products were confirmed by electrophoresis on 1% agarose gels. The purified fragments were sequenced using the Sanger sequencing platform provided by Microsynth Seqlab (Göttingen, Germany). The identity of bacterial isolates was assigned by comparing the obtained DNA sequences with those of type strains available from the GenBank NCBI (National Center for Biotechnology Information, Bethesda (MD), USA) database applying BLAST (Basic Local Alignment Search Tool, Bethesda (MD), USA, https://blast.ncbi.nlm.nih.gov/Blast.cgi, accessed on 10 January 2022) [30].
2.7. Sequence Data Availability
The 16S rRNA gene sequences of the bacterial isolates are available from GenBank-NCBI under the nucleotide accession numbers: OL672313-OL672331.
2.8. Statistical Analysis
Data were analyzed by ANOVA, and mean values were compared with Tukey’s test at the 5% significance level. The InfoStat/L software, v2020, Grupo InfoStat, FCA, National University of Cordoba, Argentina [31] was used for the statistical analysis.
3. Results
3.1. Isolation of Bacteria from Blueberry
Initially, 22 different bacterial strains were isolated, of which 18 were isolated from LB agar, and 4 originated from the enriched LBAr medium. However, from the latter, only one isolate was able to grow in LB liquid medium and could be included in the continuing assays. Hence, 19 bacterial strains were further analyzed, of which 12 originated from blueberry flowers and 7 from berries (Table 1).
Table 1.
Identification of bacterial isolates from blueberries based on 16S rRNA gene sequencing.
3.2. Molecular Identification
Representatives of three different phyla were disclosed among isolates: Proteobacteria (11), Firmicutes (5), and Actinobacteria (3). Altogether, members of eleven different genera were identified: Rosenbergiella (4), Fictibacillus (3), Bacillus (2), Pseudomonas (2), Microbacterium (2), Asaia (1), Acinetobacter (1), Curtobacterium (1), Serratia (1), Sphingomonas (1), and Xylophilus (1) (Table 1).
3.3. In Vitro Antagonism against Blueberry Pathogenic Fungi
In our preliminary tests (dual culture assays outlined in Material and Methods), eight strains displayed antagonistic activities against B. cinerea, whereas six strains obstructed the growth of A. alternata. Three isolates, i.e., BA3, BA4, and BMEF1, depicted retarding activities directed at both fungi (Table 2).
Table 2.
In vitro preliminary screening of bacterial isolates obtained by the dual culture assay with B. cinerea and A. alternata as the test organisms.
The eleven strains displaying any inhibiting activities in the above assay (BA3, BA4, BA6, BF2, BF3, BF5, BF6, BF7, BF9, BF14, and BMEF1) were subjected to the parallel streak method to quantify fungal growth inhibition by measuring mycelial growth after 10 and 7 days for B. cinerea (Figure 1) and A. alternata (Figure 2), respectively. From the eight strains inhibiting B. cinerea, BA3 and BA4 caused a growth impairment of over 80%; BMEF1 and BF5 caused an inhibition between 50 and 80%; BA6, BF7, BF9, and BF14 showed a lesser inhibition (10%). From the six strains harming A. alternata, BA4 inhibited growth by over 80%; strains BA3, BMEF1, BF2, and BF3 produced a growth impairment from 50 to 80%; BF6 revealed 10% inhibition.
Figure 1.
In vitro inhibitory activities of isolated bacteria against B. cinerea on PDA medium after 10 days of incubation at 25 °C. (i) Plates inoculated with the pathogen and bacterial strains: Asaia spathodeae BMEF1 (A), Pseudomonas tremae BF5 (B), Microbacterium testaceum BF7 (C), Curtobacterium pusillum BF9 (D), Serratia marcescens BF14 (E), Bacillus velezensis BA3 (F), B. velezensis BA4 (G), Sphingomonas zeae BA6 (H), respectively. (I) Control plate inoculated only with B. cinerea. (ii) Growth inhibition of B. cinerea confronted with bacterial isolates in dual culture assay. Different letters above the bars indicate significant differences according to Tukey’s test (p < 0.05).
Figure 2.
(i) In vitro inhibitory activities of isolated bacteria against A. alternata on PDA medium after 7 days of incubation at 25 °C.Plates inoculated with the pathogen and bacterial strains: Rosenbergiella epipactidis BF2 (A), Rosenbergiella epipactidis BF3 (B), A. spathodeae BMEF1 (C), B. velezensis BA3 (D), B. velezensis BA4 (E), respectively. (F) Control plate inoculated only with the fungus. (ii) Growth inhibition of A. alternata confronted with bacterial isolates in dual culture assay. Different letters above the bars indicate significant differences according to Tukey’s test (p < 0.05).
3.4. In Vivo Biocontrol Capacities
In vivo assays targeted at B. cinerea were conducted using blueberry fruits (as outlined in Material and Methods) using the eight selected isolates shown above (Table 2). After 7 days of incubation at 25 °C, B. velezensis BA3, B. velezensis BA4, A. spathodeae BMEF1, and P. tremae BF5 produced protection efficiencies greater than 60% (Figure 3). The strains S. zeae BA6, M. testaceum BF7, C. pusillum BF9, and S. marcescens BF14 showed no significant effects in protecting the fruits against the fungus.
Figure 3.
In vivo protection efficiency assay. (i) Blueberries artificially infected with B. cinerea after 7 days incubation at 25 °C. Fruits were pretreated as described in Material and Methods with strains B. velezensis BA4 (A); B. velezensis BA3 (B), P. tremae BF5 (C), A. spathodeae BMEF1 (D), and M. testaceum BF7 (E), respectively. Control: fruits only inoculated with the pathogen (F). (ii) Protection efficiency of bacteria against B. cinerea in the in vivo assay. The 8 isolates producing B. cinerea growth inhibition in vitro (Table 2) were evaluated for their capacity to inhibit the fungus on blueberry fruits after 7 days of incubation at 25 °C. Different letters above the bars indicate significant differences by Tukey’s test (p < 0.05).
4. Discussion
The lack of specific biocontrol agents facilitating the obviation of postharvest fungal infestations of blueberries, along with the drawbacks brought about by the use of synthetic fungicides, encouraged our study to find alternative biocontrol prospects. We looked for native bacteria from blueberries with the potential to exert antagonistic activities on the two most significant fungi with respect to crop losses, B. cinerea and A. alternata.
Since blueberry flowers and fruits are the plant organs most severely affected by the above fungal pathogens, we focused on biocontrol agents originating from the same environment in which they are destined to be finally applied, thereby widely ensuring both adaptation and survival [23,32]. In addition to non-supplemented medium (LB) a culture medium enriched with blueberry juice to mimic the natural environment of the fruit was employed (LBAr), but only one isolate could be further cultivated from the latter. Presumably, there are ingredients in the blueberry juice essential for some species that are lacking in the non-supplemented medium. Experiments to identify and characterize such substances are in progress.
To the best of our knowledge, this is the first report on the isolation and characterization of epiphytic bacteria with biocontrol potential from blueberry flowers and fruits.
The dual culture assay in our study again proved successful as a valuable qualitative approach to quickly assess antagonistic activities of microorganisms directed at fungal postharvest phytopathogens [25,33,34,35,36].
Paradigmatic testing of the protection efficiency of the different bacterial isolates against B. cinerea by in vivo application of both the bacterial strain and the fungus directly on the wounded fruits was carried out in a way that took into account a significant factor for commercialization. To date, most reports applied inoculation of the biocontrol agent directly at the wounded site [35,37,38,39,40]. Although being a quick and straightforward strategy, it is hardly compatible with conventional application conditions during fruit packaging. The spraying method applied in this study meets the producer´s requirements almost perfectly. From the sequence analysis of a part of the 16S rRNA gene, the three strains displaying the most persuasive antagonistic effects against both fungi were identified as B. velezensis (BA3 and BA4) and A. spathodeae (BMEF1). Inhibiting activities directed at different phytopathogens qualifies such candidates for the composition of a broad-spectrum biofungicide aimed at combating postharvest diseases. Studies on combined, possibly synergistic actions are in progress. The compelling antagonistic capacities of B. velezensis BA3 and BA4 agree with a number of literature reports focusing on biocontrol capabilities of species belonging to the genus Bacillus, which excel in their ability to produce a wide range of bioactive antimicrobial substances such as lipopeptides, antibiotics, enzymes, polyketides, and non-ribosomal proteins [36,41,42,43]. Since the members of the genus are characterized by their ability to produce heat, drought, and solvent-tolerant endospores, they are, with respect to durability, almost ideally suited for their inclusion in biocontrol formulations [44,45]. Previously, B. velezensis was a heterotypic synonym of B. amyloliquefaciens, based on DNA–DNA relatedness values. Currently, B. velezensis can be distinguished from B. amyloliquefaciens and B. subtilis based on multilocus sequence analysis [46].
Interestingly, there are rather recent reports presumably widening the range of the B. velezensis BA3 and BA4 disease-controlling efficacy and emphasizing their relevance as biocontrol agents: Kim et al. (2021) [47] reported on the activity of B. velezensis AK-0 against Colletotrichum gloeosporoides, the causal agent of apple bitter rot, while Palazzini et al. (2016) [48] demonstrated, in greenhouse and field trials, the ability of B. velezensis RC 218 to reduce the disease severity of the Fusarium head blight along with the diminution of deoxynivalenol, a disease-associated toxin. Moreover, B. velezensis NKG2 displayed in vitro antagonistic effects against several important fungal plant pathogens such as B. cinerea, A. alternata, Fusarium graminareum, Fusarium oxysporum, Fulvia fulva, and Ustilaginosa virens [49]. Thus, our results not only agree with the above reports on in vitro bioactivities of the species, but for the first time, antifungal B. velezensis strains were isolated from and tested against blueberry pathogens in vitro and in vivo.
A. spathodeae was, agreeing with the species designation, first isolated from flowers of Spathodea campanulata, the African tulip [50]. Studies on antagonistic activities are lacking to date. Thus, our results indicated that members of the species have antifungal activity and opened the avenue for application of BMEF1 as a biocontrol agent.
Although not as pronounced as for A. spathodeae, BMEF1 bioactivity against agriculturally important fungal species could also be attributed, for the first time, to strains of other, only rather recently discovered species, i.e., Rosenbergiella epipactidis [51] strains BF2, BF3, and BF6.
In conclusion, two native strains of B. velezensis originating from blueberry fruits and one strain of A. spathodeae from blueberry flowers displaying capacities to control the phytopathogenic fungi Botrytis and Alternaria, respectively, were isolated. These three strains are candidates for serving as biological control agents for local blueberry production. Future studies will focus on action mechanisms facilitating biological control by searching for bioactive compounds. In addition, the sequencing of the entire genome of the candidates will contribute to the identification and understanding of the genetic and physiological mechanisms involved in controlling effects on phytopathogenic fungi.
Author Contributions
Conceptualization, J.R.D. and R.D.; methodology, F.I.C., P.E.S., F.I.M., M.M.P., M.A.D., S.I.V., A.P. and J.R.D.; software, P.E.S.; formal analysis, F.I.C. and P.E.S.; investigation, F.I.C., P.E.S., F.I.M., M.M.P., M.A.D. and A.P.; resources, R.D. and J.R.D.; data curation P.E.S.; writing—original draft preparation, F.I.C., F.M, R.D. and J.R.D.; writing—review and editing F.I.C., F.M., R.D. and J.R.D.; visualization, F.I.C. and P.E.S.; supervision, R.D. and J.R.D.; project administration, R.D. and J.R.D.; funding acquisition, R.D. and J.R.D. All authors have read and agreed to the published version of the manuscript.
Funding
This research was partially funded by PICT 2018 N° 2545 PRESTAMO BID and PIUNT A618/2. We acknowledge support by the Open Access Publication Funds of the University of Göttingen. The funders had no role in study design, data collection, and interpretation, or the decision to submit the work for publication.
Institutional Review Board Statement
Not applicable.
Informed Consent Statement
Not applicable.
Data Availability Statement
Not applicable.
Acknowledgments
We are grateful to Victor Hugo Baigorria for his assistance in field trips. We also thank Ing. Santiago Frias Alurralde and Tierra de Arándanos for providing access to blueberry crops and procurement of fresh fruit. J.R.D. and P.E.S. gratefully acknowledge the support by the Alexander von Humboldt Foundation.
Conflicts of Interest
The authors declare no conflict of interest. The funders had no role in the design of the study; in the collection, analyses, or interpretation of data; in the writing of the manuscript, or in the decision to publish the results.
References
- Kloet, S.P.V. The taxonomy of the highbush blueberry, Vaccinium corymbosum. Can. J. Bot. 1980, 58, 1187–1201. [Google Scholar] [CrossRef]
- Ma, L.; Sun, Z.; Zeng, Y.; Luo, M.; Yang, J. Molecular mechanism and health role of functional ingredients in blueberry for chronic disease in human beings. Int. J. Mol. Sci. 2018, 19, 2785. [Google Scholar] [CrossRef] [PubMed] [Green Version]
- Davidson, K.T.; Zhu, Z.; Balabanov, D.; Zhao, L.; Wakefield, M.R.; Bai, Q.; Fang, Y. Beyond conventional medicine—A look at blueberry, a cancer-fighting superfruit. Pathol. Oncol. Res. 2018, 24, 733–738. [Google Scholar] [CrossRef] [PubMed]
- Giacalone, M.; di Sacco, F.; Traupe, I.; Topini, R.; Forfori, F.; Giunta, F. Antioxidant and neuroprotective properties of blueberry polyphenols: A critical review. Nutr. Neurosci. 2011, 14, 119–125. [Google Scholar] [CrossRef]
- Neto, C.C. Cranberry and Blueberry: Evidence for protective effects against cancer and vascular diseases. Mol. Nutr. Food Res. 2007, 51, 652–664. [Google Scholar] [CrossRef]
- Dell’Acqua, A.; Moyano, M.B.; Galvan, J.; Gonzalez, L.R.D.; Paz, C. Comercialización Y Competitividad Del Arándano Argentino; Inta, E., Ed.; INTA Ediciones: Buenos Aires, Argentina, 2019. [Google Scholar]
- Munitz, M.S.; Garrido, C.E.; Gonzalez, H.H.L.; Resnik, S.L.; Salas, P.M.; Montti, M.I.T. Mycoflora and potential mycotoxin production of freshly harvested blueberry in concordia, Entre Ríos province, Argentina. Int. J. Fruit Sci. 2013, 13, 312–325. [Google Scholar] [CrossRef]
- Smith, B.J.; Magee, J.B.; Gupton, C.L. Susceptibility of Rabbiteye Blueberry cultivars to postharvest diseases. Plant Dis. 1996, 80, 215–218. [Google Scholar] [CrossRef]
- Zhu, X.Q.; Xiao, C.L. Phylogenetic, morphological, and pathogenic characterization of Alternaria species associated with fruit rot of blueberry in California. Phytopathology 2015, 105, 1555–1567. [Google Scholar] [CrossRef] [Green Version]
- Vasquez, P.; Baldomá, J.; Wright, E.; Pérez, A.; Sesar, M.D.D.; Pérez, B. First report of blueberry Botrytis blight in Buenos Aires, Entre Ríos, and Córdoba, Argentina. Plant Dis. 2007, 91, 639. [Google Scholar] [CrossRef]
- Romanazzi, G.; Feliziani, E. Botrytis cinerea (Gray Mold). In Postharvest Decay: Control Strategies; Press, A., Ed.; Elsevier: Amsterdam, The Netherlands, 2014; pp. 131–146. ISBN 9780124115682. [Google Scholar]
- Williamson, B.; Tudzynski, B.; Tudzynski, P.; Van Kan, J.A.L. Botrytis cinerea: The cause of grey mould disease. Mol. Plant Pathol. 2007, 8, 561–580. [Google Scholar] [CrossRef]
- Thomma, B.P.H.J. Alternaria spp.: From general saprophyte to specific parasite. Mol. Plant Pathol. 2003, 4, 225–236. [Google Scholar] [CrossRef]
- Milholland, R.; Jones, R. Postharvest decay of highbush blueberry fruit in North- Carolina. Plant Dis. Report. 1972, 56, 118. [Google Scholar]
- Pérez, E.; Blanco, O.; Alves, P.; Román, C.; Rial, M.; Rodríguez, A.; Heredia, A.M. Guía Para la Identificación de Patógenos de Poscosecha en Frutos de Arándanos; INIA: Salto, Uruguay, 2014; ISBN 9789974383623. [Google Scholar]
- Saito, S.; Michailides, T.J.; Xiao, C.L. Fungicide resistance profiling in Botrytis cinerea populations from blueberry in California and Washington and their impact on control of gray mold. Plant Dis. 2016, 100, 2087–2093. [Google Scholar] [CrossRef] [Green Version]
- Droby, S.; Lichter, A. Post-harvest Botrytis infection: Etiology, development and management. In Botrytis: Biology, Pathology and Control; Springer: Berlin/Heidelberg, Germany, 2007; pp. 349–367. [Google Scholar] [CrossRef]
- Leroux, P. Chemical control of Botrytis and its resistance to chemical fungicides. In Botrytis: Biology, Pathology and Control; Springer: Berlin/Heidelberg, Germany, 2007; pp. 195–222. [Google Scholar] [CrossRef]
- Pereyra, M.M.; Díaz, M.A.; Soliz-Santander, F.F.; Poehlein, A.; Meinhardt, F.; Daniel, R.; Dib, J.R. Screening methods for isolation of biocontrol epiphytic yeasts against Penicillium digitatum in lemons. J. Fungi 2021, 7, 166. [Google Scholar] [CrossRef]
- Díaz, M.A.; Pereyra, M.M.; Picón-Montenegro, E.; Meinhardt, F.; Dib, J.R. Killer yeasts for the biological control of postharvest fungal crop diseases. Microorganisms 2020, 8, 1680. [Google Scholar] [CrossRef]
- Palou, L.; Smilanick, J.L.; Droby, S. Alternatives to conventional fungicides for the control of citrus postharvest green and blue moulds. Stewart Postharvest Rev. 2008, 4, 1–16. [Google Scholar] [CrossRef]
- Droby, S.; Wisniewski, M. The fruit microbiome: A new frontier for postharvest biocontrol and postharvest biology. Postharvest Biol. Technol. 2018, 140, 107–112. [Google Scholar] [CrossRef]
- Wilson, C.L.; Wisniewski, M.E. Biological control of postharvest diseases of fruits and vegetables: An emerging technology. Annu. Rev. Phytopathol. 1989, 27, 425–441. [Google Scholar] [CrossRef]
- Abbey, J.A.; Percival, D.; Abbey, L.; Asiedu, S.K.; Prithiviraj, B.; Schilder, A. Biofungicides as alternative to synthetic fungicide control of grey mould (Botrytis cinerea)—Prospects and challenges. Biocontrol Sci. Technol. 2018, 29, 241–262. [Google Scholar] [CrossRef]
- Raymaekers, K.; Ponet, L.; Holtappels, D.; Berckmans, B.; Cammue, B.P.A. Screening for novel biocontrol agents applicable in plant disease management—A review. Biol. Control 2020, 144, 104240. [Google Scholar] [CrossRef]
- De Lima, J.R.; Gonçalves, L.R.B.; Brandão, L.R.; Rosa, C.A.; Viana, F.M.P. Isolation, identification, and activity in vitro of killer yeasts against Colletotrichum gloeosporioides isolated from tropical Fruits. J. Basic Microbiol. 2012, 52, 1–10. [Google Scholar] [CrossRef]
- Olmedo, G.M. Acción antifúngica de compuestos químicos sobre hongos fitopatógenos que afectan frutos de interés regional. Ph.D. Thesis, Universidad Nacional de Tucumán, San Miguel de Tucumán, Argentina, 2017. [Google Scholar]
- Johnson, J.S.; Spakowicz, D.J.; Hong, B.Y.; Petersen, L.M.; Demkowicz, P.; Chen, L.; Leopold, S.R.; Hanson, B.M.; Agresta, H.O.; Gerstein, M.; et al. Evaluation of 16S RRNA gene sequencing for species and strain-level microbiome analysis. Nat. Commun. 2019, 10, 5029. [Google Scholar] [CrossRef] [Green Version]
- Fredriksson, N.J.; Hermansson, M.; Wilén, B.M. The choice of PCR primers has great impact on assessments of bacterial community diversity and dynamics in a wastewater treatment plant. PLoS ONE 2013, 8, e76431. [Google Scholar] [CrossRef]
- Altschul, S.F.; Gish, W.; Miller, W.; Myers, E.W.; Lipman, D.J. Basic Local Alignment Search Tool. J. Mol. Biol. 1990, 215, 403–410. [Google Scholar] [CrossRef]
- Di Rienzo, J.; Casanoves, F.; Balzarini, M.; Gonzalez, L.; Tablada, M.; Robledo, C. InfoStat, versión 2020. Software for Statistical Analysis for Windows. 10 January. Available online: http://www.infostat.com.ar (accessed on 10 January 2022).
- Sharma, R.R.; Singh, D.; Singh, R. Biological control of postharvest diseases of fruits and vegetables by microbial antagonists: A review. Biol. Control 2009, 50, 205–221. [Google Scholar] [CrossRef]
- Calvo, J.; Calvente, V.; de Orellano, M.E.; Benuzzi, D.; de Tosetti, M.I.S. Biological control of postharvest spoilage caused by Penicillium expansum and Botrytis cinerea in apple by using the bacterium Rahnella aquatilis. Int. J. Food Microbiol. 2007, 113, 251–257. [Google Scholar] [CrossRef]
- Wang, S.; Hu, T.; Jiao, Y.; Wei, J.; Cao, K. Isolation and characterization of Bacillus subtilis EB-28, an endophytic bacterium strain displaying biocontrol activity against Botrytis cinerea Pers. Front. Agric. China 2009, 3, 247–252. [Google Scholar] [CrossRef]
- Kurniawan, O.; Wilson, K.; Mohamed, R.; Avis, T.J. Bacillus and Pseudomonas spp. provide antifungal activity against Gray Mold and Alternaria Rot on blueberry Fruit. Biol. Control 2018, 126, 136–141. [Google Scholar] [CrossRef]
- Li, X.; Zhang, M.; Qi, D.; Zhou, D.; Qi, C.; Li, C.; Liu, S.; Xiang, D.; Zhang, L.; Xie, J.; et al. Biocontrol ability and mechanism of a broad-spectrum antifungal strain Bacillus safensis sp. QN1NO-4 against strawberry anthracnose caused by Colletotrichum fragariae. Front. Microbiol. 2021, 12, 1–14. [Google Scholar] [CrossRef] [PubMed]
- Parafati, L.; Vitale, A.; Restuccia, C.; Cirvilleri, G. Biocontrol ability and action mechanism of food-isolated yeast strains against Botrytis cinerea causing Post-Harvest bunch rot of table grape. Food Microbiol. 2015, 47, 85–92. [Google Scholar] [CrossRef]
- Chen, X.; Wang, Y.; Gao, Y.; Gao, T.; Zhang, D. Inhibitory abilities of Bacillus isolates and their culture filtrates against the gray mold caused by Botrytis cinerea on postharvest fruit. Plant Pathol. J. 2019, 35, 425–436. [Google Scholar] [CrossRef]
- Li, W.; Long, Y.; Mo, F.; Shu, R.; Yin, X.; Wu, X.; Zhang, R.; Zhang, Z.; He, L.; Chen, T.; et al. Antifungal activity and biocontrol mechanism of Fusicolla violacea J-1 against soft rot in kiwifruit caused by Alternaria alternata. J. Fungi 2021, 7, 937. [Google Scholar] [CrossRef]
- Saravanakumar, D.; Ciavorella, A.; Spadaro, D.; Garibaldi, A.; Gullino, M.L. Metschnikowia pulcherrima strain MACH1 outcompetes Botrytis cinerea, Alternaria alternata and Penicillium expansum in apples through iron depletion. Postharvest Biol. Technol. 2008, 49, 121–128. [Google Scholar] [CrossRef]
- Caulier, S.; Nannan, C.; Gillis, A.; Licciardi, F.; Bragard, C.; Mahillon, J. Overview of the antimicrobial compounds produced by members of the Bacillus subtilis Group. Front. Microbiol. 2019, 10, 302. [Google Scholar] [CrossRef] [Green Version]
- Harwood, C.R.; Mouillon, J.M.; Pohl, S.; Arnau, J. Secondary metabolite production and the safety of industrially important members of the Bacillus subtilis group. FEMS Microbiol. Rev. 2018, 42, 721–738. [Google Scholar] [CrossRef]
- Jeong, M.H.; Lee, Y.S.; Cho, J.Y.; Ahn, Y.S.; Moon, J.H.; Hyun, H.N.; Cha, G.S.; Kim, K.Y. Isolation and characterization of metabolites from Bacillus licheniformis MH48 with antifungal activity against plant pathogens. Microb. Pathog. 2017, 110, 645–653. [Google Scholar] [CrossRef]
- Lastochkina, O.; Seifikalhor, M.; Aliniaeifard, S.; Baymiev, A. Bacillus spp.: Efficient biotic strategy to control postharvest diseases of fruits and vegetables. Plants 2019, 8, 97. [Google Scholar] [CrossRef] [Green Version]
- Shafi, J.; Tian, H.; Ji, M. Bacillus species as versatile weapons for plant pathogens: A review. Biotechnol. Biotechnol. Equip. 2017, 31, 446–459. [Google Scholar] [CrossRef] [Green Version]
- Yin, X.; Li, T.; Jiang, X.; Tang, X.; Zhang, J.; Yuan, L.; Wei, Y. Suppression of grape white rot caused by Coniella vitis using the potential biocontrol agent Bacillus Velezensis GSBZ09. Pathogens 2022, 11, 248. [Google Scholar] [CrossRef]
- Kim, Y.S.; Lee, Y.; Cheon, W.; Park, J.; Kwon, H.T.; Balaraju, K.; Kim, J.; Yoon, Y.J.; Jeon, Y. Characterization of Bacillus velezensis AK-0 as a biocontrol agent against apple bitter rot caused by Colletotrichum gloeosporioides. Sci. Rep. 2021, 11, 626. [Google Scholar] [CrossRef]
- Palazzini, J.M.; Dunlap, C.A.; Bowman, M.J.; Chulze, S.N. Bacillus velezensis RC 218 as a biocontrol agent to reduce Fusarium head blight and deoxynivalenol accumulation: Genome sequencing and secondary metabolite cluster profiles. Microbiol. Res. 2016, 192, 30–36. [Google Scholar] [CrossRef]
- Myo, E.M.; Liu, B.; Ma, J.; Shi, L.; Jiang, M.; Zhang, K.; Ge, B. Evaluation of Bacillus velezensis NKG-2 for bio-control activities against fungal diseases and potential plant growth promotion. Biol. Control 2019, 134, 23–31. [Google Scholar] [CrossRef]
- Tanasupawat, S.; Kommanee, J.; Malimas, T.; Yukphan, P.; Nakagawa, Y.; Yamada, Y. Identification of Acetobacter, Gluconobacter, and Asaia strains isolated in Thailand based on 16S-23S rRNA gene internal transcribed spacer restriction and 16S rRNA gene sequence analyses. Microbes Environ. 2009, 24, 135–143. [Google Scholar] [CrossRef] [Green Version]
- Lenaerts, M.; Álvarez-Pérez, S.; de Vega, C.; Van Assche, A.; Johnson, S.D.; Willems, K.A.; Herrera, C.M.; Jacquemyn, H.; Lievens, B. Rosenbergiella australoborealis sp. nov., Rosenbergiella collisarenosi sp. nov. and Rosenbergiella epipactidis sp. nov., three novel bacterial species isolated from floral nectar. Syst. Appl. Microbiol. 2014, 37, 402–411. [Google Scholar] [CrossRef]
Publisher’s Note: MDPI stays neutral with regard to jurisdictional claims in published maps and institutional affiliations. |
© 2022 by the authors. Licensee MDPI, Basel, Switzerland. This article is an open access article distributed under the terms and conditions of the Creative Commons Attribution (CC BY) license (https://creativecommons.org/licenses/by/4.0/).